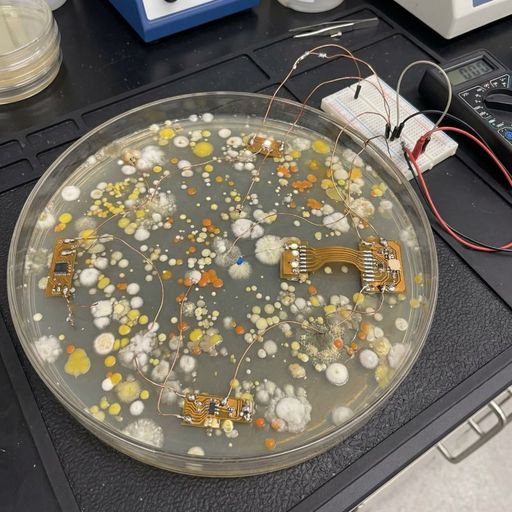
MOLDAGENT

Dasar
Spot
Perdagangkan kripto dengan bebas
Perdagangan Margin
Perbesar keuntungan Anda dengan leverage
Konversi & Investasi Otomatis
0 Fees
Perdagangkan dalam ukuran berapa pun tanpa biaya dan tanpa slippage
ETF
Dapatkan eksposur ke posisi leverage dengan mudah
Perdagangan Pre-Market
Perdagangkan token baru sebelum listing
Futures
Akses ribuan kontrak perpetual
TradFi
Emas
Satu platform aset tradisional global
Opsi
Hot
Perdagangkan Opsi Vanilla ala Eropa
Akun Terpadu
Memaksimalkan efisiensi modal Anda
Perdagangan Demo
Pengantar tentang Perdagangan Futures
Bersiap untuk perdagangan futures Anda
Acara Futures
Gabung acara & dapatkan hadiah
Perdagangan Demo
Gunakan dana virtual untuk merasakan perdagangan bebas risiko
Peluncuran
CandyDrop
Koleksi permen untuk mendapatkan airdrop
Launchpool
Staking cepat, dapatkan token baru yang potensial
HODLer Airdrop
Pegang GT dan dapatkan airdrop besar secara gratis
Launchpad
Jadi yang pertama untuk proyek token besar berikutnya
Poin Alpha
Perdagangkan aset on-chain, raih airdrop
Poin Futures
Dapatkan poin futures dan klaim hadiah airdrop
Investasi
Simple Earn
Dapatkan bunga dengan token yang menganggur
Investasi Otomatis
Investasi otomatis secara teratur
Investasi Ganda
Keuntungan dari volatilitas pasar
Soft Staking
Dapatkan hadiah dengan staking fleksibel
Pinjaman Kripto
0 Fees
Menjaminkan satu kripto untuk meminjam kripto lainnya
Pusat Peminjaman
Hub Peminjaman Terpadu